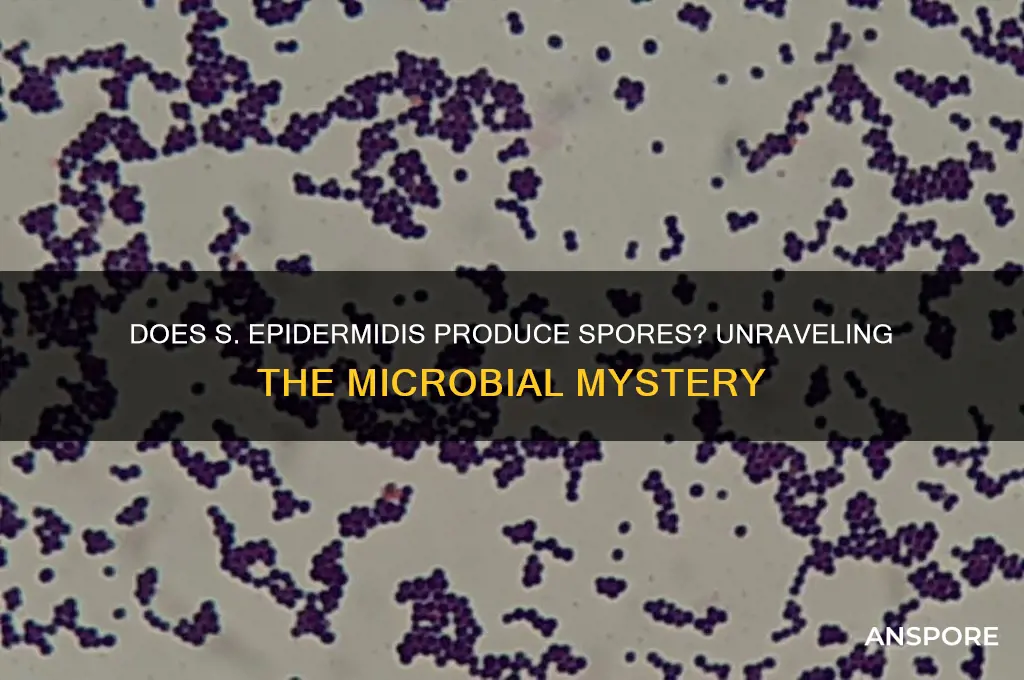
does s epidermitis have spores

*Staphylococcus epidermidis*, a common commensal bacterium found on human skin, is known for its ability to form biofilms, which contribute to its role in hospital-acquired infections, particularly in medical device-related infections. While *S. epidermidis* is a well-studied organism, it does not produce spores. Spores are a characteristic feature of certain bacteria, such as *Bacillus* and *Clostridium* species, which form them as a survival mechanism in harsh conditions. In contrast, *S. epidermidis* relies on its biofilm-forming capabilities and resistance to antibiotics for survival, rather than spore formation. Understanding this distinction is crucial for effective infection control and treatment strategies.
| Characteristics | Values |
|---|---|
| Does S. epidermidis have spores? | No |
| Type of Bacteria | Gram-positive coccus |
| Sporulation Ability | Non-sporulating |
| Reproduction | Asexual (binary fission) |
| Habitat | Skin flora of humans and animals |
| Pathogenicity | Opportunistic pathogen, can cause infections in immunocompromised individuals or with indwelling medical devices |
| Antibiotic Resistance | Known for developing resistance to multiple antibiotics, including methicillin (MRSE) |
| Role in Skin | Part of normal skin microbiota, helps maintain skin health by competing with pathogens |
| Metabolism | Facultative anaerobe, can survive with or without oxygen |
| Cell Arrangement | Typically found in clusters or pairs (grape-like clusters) |
| Relevance in Medicine | Common cause of hospital-acquired infections, particularly in catheter-related infections |
Explore related products
What You'll Learn
- S. epidermidis spore formation: Does this bacterium naturally produce spores under any conditions
- Sporulation triggers: Are there specific environmental factors that induce spore formation in S. epidermidis
- Spore detection methods: How can spores of S. epidermidis be identified in clinical samples
- Clinical relevance of spores: Do S. epidermidis spores play a role in infections or antibiotic resistance
- Comparative sporulation: How does S. epidermidis sporulation differ from other spore-forming bacteria

S. epidermidis spore formation: Does this bacterium naturally produce spores under any conditions?
Observation: *Staphylococcus epidermidis* is a ubiquitous commensal bacterium commonly found on human skin, yet its ability to form spores remains a topic of scientific inquiry. Unlike its close relative *Bacillus anthracis*, which is known for spore production, *S. epidermidis* has not been observed to naturally produce spores under standard laboratory conditions. This distinction is critical, as spore formation is a survival mechanism that allows bacteria to withstand harsh environments, such as extreme temperatures, desiccation, and antimicrobial agents.
Analytical Insight: Sporulation in bacteria is a complex, energy-intensive process regulated by specific genetic pathways. While *S. epidermidis* possesses a robust ability to form biofilms and adapt to stress, there is no evidence of sporulation genes in its genome. Studies using advanced genomic sequencing and transcriptomic analysis have consistently failed to identify homologs of sporulation-related genes found in spore-forming bacteria like *Bacillus* or *Clostridium*. This absence suggests that *S. epidermidis* lacks the biological machinery required for spore formation.
Practical Implications: Clinically, the inability of *S. epidermidis* to form spores is significant. Spores are notoriously difficult to eradicate due to their resistance to antibiotics and disinfectants. Since *S. epidermidis* does not produce spores, infection control strategies can focus on disrupting biofilms and targeting planktonic cells. For example, in healthcare settings, the use of antiseptics like chlorhexidine or ethanol-based hand sanitizers remains effective against *S. epidermidis* biofilms, reducing the risk of device-related infections.
Comparative Perspective: Unlike spore-forming pathogens, *S. epidermidis* relies on biofilm formation and phenotypic plasticity for survival. Biofilms provide a protective matrix that shields cells from host immune responses and antimicrobials, but they are more susceptible to mechanical disruption compared to spores. This difference highlights the importance of tailoring infection control measures to the specific survival strategies of the bacterium in question.
Takeaway: While *S. epidermidis* is a resilient bacterium, its survival mechanisms do not include spore formation. Understanding this limitation allows for more targeted and effective strategies to manage infections caused by this organism. Future research should focus on identifying novel ways to disrupt *S. epidermidis* biofilms and prevent its adaptation to antimicrobial agents, rather than addressing hypothetical spore-related challenges.
Can Spore Run on Windows 8 via Steam? Compatibility Guide
You may want to see also

Sporulation triggers: Are there specific environmental factors that induce spore formation in S. epidermidis?
Staphylococcus epidermidis, a common commensal bacterium found on human skin, is not typically known for spore formation. Unlike its close relative, Bacillus species, S. epidermidis lacks the genetic machinery required for sporulation under normal conditions. However, recent studies have explored whether specific environmental stressors might induce a dormant or spore-like state in this bacterium. Understanding such triggers could have implications for its survival in clinical settings and its role in biofilm-associated infections.
Environmental stressors such as nutrient deprivation, pH shifts, and exposure to antimicrobial agents are known to induce adaptive responses in bacteria. For S. epidermidis, nutrient limitation, particularly the depletion of carbon and nitrogen sources, has been investigated as a potential sporulation trigger. While true sporulation does not occur, these conditions can lead to a reduction in metabolic activity and increased resistance to antibiotics, mimicking a spore-like survival strategy. For instance, studies have shown that S. epidermidis exposed to glucose deprivation for 48 hours exhibits a 30% decrease in metabolic activity, enhancing its persistence in hostile environments.
Another factor to consider is oxygen availability. S. epidermidis is facultative anaerobic, meaning it can survive in both aerobic and anaerobic conditions. However, prolonged exposure to anaerobic environments, such as those found in deep tissue infections or medical devices, may trigger a stress response akin to sporulation. In one study, S. epidermidis cultures grown under anaerobic conditions for 72 hours demonstrated a twofold increase in biofilm formation, a mechanism often associated with survival under stress. This suggests that oxygen deprivation could act as a sporulation-like trigger, promoting long-term survival.
Temperature fluctuations also play a role in inducing stress responses in S. epidermidis. Exposure to suboptimal temperatures, such as 4°C, has been shown to slow bacterial growth and alter cell wall composition, potentially enhancing resistance to environmental challenges. While this does not constitute sporulation, it highlights the bacterium’s ability to adapt to harsh conditions through alternative mechanisms. Clinically, this adaptation is significant, as it may contribute to the persistence of S. epidermidis in refrigerated medical equipment or during cold storage of biological samples.
In conclusion, while S. epidermidis does not form spores, specific environmental factors such as nutrient deprivation, anaerobic conditions, and temperature shifts can induce stress responses that mimic sporulation. These adaptations enhance the bacterium’s survival in adverse environments, posing challenges in clinical and industrial settings. Understanding these triggers is crucial for developing effective strategies to control S. epidermidis infections and biofilm formation, particularly in healthcare contexts where its persistence is a concern.
Does Milky Spore Harm Beneficial Grubs in Your Lawn?
You may want to see also

Spore detection methods: How can spores of S. epidermidis be identified in clinical samples?
Staphylococcus epidermidis, a common commensal bacterium, is not typically known to produce spores under normal conditions. However, in certain stressful environments, such as nutrient deprivation or exposure to antimicrobials, some strains may exhibit spore-like structures or enter a dormant state. Detecting these spore-like forms in clinical samples is crucial for accurate diagnosis and treatment, especially in healthcare settings where S. epidermidis is a leading cause of biofilm-associated infections. Below are specific methods and considerations for identifying spore-like structures of S. epidermidis in clinical samples.
Microscopic Examination and Staining Techniques
One of the primary methods for detecting spore-like structures involves microscopic analysis combined with specialized staining. Heat-resistant spores can be visualized using the Schaeffer-Fulton stain, which differentiates spores (green) from vegetative cells (red). For S. epidermidis, this technique may reveal dormant or stress-induced forms that resemble spores. Phase-contrast microscopy can also be employed to observe cellular morphology changes indicative of dormancy. However, these methods require skilled interpretation, as S. epidermidis spores are not as distinct as those of Bacillus or Clostridium species.
Molecular Detection and PCR-Based Assays
Molecular techniques offer a more precise approach to identifying spore-like forms of S. epidermidis. PCR assays targeting genes associated with sporulation or stress response pathways, such as *sigB* (a stress response regulator), can be utilized. For example, primers designed to amplify *sigB* or other dormancy-related genes can confirm the presence of spore-like cells in clinical samples. Quantitative PCR (qPCR) allows for the quantification of these cells, providing insights into their prevalence in biofilms or infected tissues. This method is particularly useful in research settings but requires validation for clinical use.
Culture-Based Methods and Stress Induction
To induce and detect spore-like forms, clinical samples can be subjected to stress conditions in vitro. Nutrient deprivation, high salinity, or exposure to sublethal concentrations of antimicrobials can trigger dormancy in S. epidermidis. After stress induction, samples are cultured on selective media, such as mannitol salt agar, to isolate and identify the bacterium. Viability assays, like the propidium iodide stain, can differentiate dormant cells from dead ones. This approach is labor-intensive but provides direct evidence of spore-like survival mechanisms.
Practical Considerations and Limitations
While these methods are effective, they are not without challenges. The rarity of spore-like forms in S. epidermidis makes detection difficult, and false negatives are common. Additionally, distinguishing between true spores and dormant cells requires careful interpretation. Clinicians and lab technicians must correlate findings with patient history and clinical presentation. For instance, persistent infections despite antibiotic therapy may suggest the presence of dormant or spore-like cells, warranting further investigation.
In conclusion, detecting spore-like forms of S. epidermidis in clinical samples requires a combination of microscopic, molecular, and culture-based techniques. Each method has its strengths and limitations, and a multidisciplinary approach is often necessary for accurate identification. As research progresses, these methods will likely become more refined, improving our understanding of S. epidermidis’s survival strategies and enhancing patient care.
Milky Spore's Effectiveness: Does It Kill All Beetle Grubs?
You may want to see also
Explore related products

Clinical relevance of spores: Do S. epidermidis spores play a role in infections or antibiotic resistance?
Observation: *Staphylococcus epidermidis* is a ubiquitous commensal bacterium commonly found on human skin, yet its role in infections, particularly in immunocompromised or hospitalized patients, is well-documented. Unlike its close relative *S. aureus*, *S. epidermidis* is not traditionally known to form spores. However, recent studies have explored whether dormant or spore-like structures could contribute to its persistence in clinical settings, raising questions about their role in infections and antibiotic resistance.
Analytical Insight: The absence of spore formation in *S. epidermidis* under normal conditions is a key distinction from spore-forming pathogens like *Clostridioides difficile*. Spores are highly resistant structures that enable bacteria to survive harsh environments, including antibiotic exposure. While *S. epidermidis* lacks this classical survival mechanism, it exhibits other strategies, such as biofilm formation, to evade eradication. Biofilms, composed of extracellular polymeric substances, protect bacteria from host defenses and antibiotics, contributing to persistent infections, particularly in medical device-related infections. However, the question remains: could *S. epidermidis* harbor a dormant or spore-like state under specific stress conditions, and if so, what implications does this have for clinical management?
Instructive Guidance: Clinicians and researchers should be aware that while *S. epidermidis* does not form spores, its ability to enter a viable but non-culturable (VBNC) state under stress, such as nutrient deprivation or antibiotic exposure, may mimic spore-like behavior. In this state, the bacterium remains alive but undetectable by standard culturing methods, potentially leading to underestimated infection risks. To address this, advanced detection techniques, such as molecular methods (e.g., PCR) or metabolic assays, should be employed to identify VBNC cells in clinical samples. For patients with suspected *S. epidermidis* infections, particularly those with indwelling devices, prolonged or combination antibiotic therapy may be necessary to target both active and dormant bacterial populations.
Comparative Perspective: Unlike spore-forming bacteria, where spore germination is a critical target for therapeutic intervention, *S. epidermidis* requires a different approach. While spores of *Bacillus* or *Clostridium* species can be inactivated by heat or specific chemicals, *S. epidermidis* biofilms demand mechanical disruption or anti-biofilm agents like dispersin B or DNase. Additionally, the lack of spores in *S. epidermidis* means that antibiotic resistance is primarily driven by genetic mechanisms, such as the acquisition of resistance genes (e.g., mecA for methicillin resistance) or efflux pumps. This underscores the importance of judicious antibiotic use and infection control measures to prevent resistance in clinical settings.
Persuasive Argument: The clinical relevance of *S. epidermidis* spores, or their absence, highlights the need for a nuanced understanding of bacterial survival strategies. While spores are not a concern, the bacterium’s ability to form biofilms and enter VBNC states poses significant challenges for infection control. Hospitals and healthcare providers must prioritize preventive measures, such as rigorous sterilization of medical devices and surveillance for antibiotic resistance. Furthermore, research into novel therapies targeting biofilms and VBNC cells could revolutionize the management of *S. epidermidis* infections, reducing morbidity and mortality in vulnerable populations.
Practical Takeaway: For healthcare professionals, recognizing the spore-independent persistence of *S. epidermidis* is crucial. Implement multi-faceted strategies, including early removal of infected devices, use of anti-biofilm agents, and tailored antibiotic regimens, to combat infections effectively. Patients, particularly those with implanted devices, should be educated on signs of infection and the importance of prompt medical attention. By addressing *S. epidermidis*’s unique survival mechanisms, clinicians can improve outcomes and mitigate the growing threat of antibiotic resistance.
Steel Types and Spore Absorption: Unraveling the Myth and Facts
You may want to see also

Comparative sporulation: How does S. epidermidis sporulation differ from other spore-forming bacteria?
Staphylococcus epidermidis, a common commensal bacterium found on human skin, does not form spores under normal conditions. This contrasts sharply with spore-forming bacteria like Bacillus subtilis and Clostridium difficile, which produce highly resistant endospores as a survival mechanism. The absence of sporulation in S. epidermidis is a critical distinction, as it limits its ability to withstand extreme environmental conditions such as desiccation, heat, and chemical disinfectants. While S. epidermidis relies on biofilm formation and antibiotic resistance for survival, spore-forming bacteria use sporulation as a primary strategy to endure harsh environments for extended periods.
Analyzing the sporulation process in spore-forming bacteria reveals a complex, multi-stage mechanism. For instance, Bacillus subtilis initiates sporulation in response to nutrient deprivation, culminating in the formation of a spore with a thick, protective coat. This spore can remain dormant for years, reactivating when conditions improve. In contrast, S. epidermidis lacks the genetic machinery for sporulation, such as the *spo* genes found in Bacillus species. This genetic difference underscores why S. epidermidis cannot sporulate, even under stress. Understanding this distinction is crucial for developing targeted antimicrobial strategies, as spore-forming bacteria require specific treatments to eradicate their resilient spores.
From a practical standpoint, the inability of S. epidermidis to sporulate simplifies infection control in clinical settings. Unlike spore-forming bacteria, which necessitate high-level disinfection (e.g., 10% bleach or autoclaving at 121°C for 15 minutes), S. epidermidis can be effectively eliminated with standard disinfectants like 70% ethanol or quaternary ammonium compounds. However, its biofilm-forming capability poses a unique challenge, particularly in medical device-related infections. For example, biofilms on catheters or prosthetics require aggressive mechanical removal or antimicrobial lock therapy (e.g., 2% citric acid or 0.9% sodium chloride with vancomycin) to prevent recurrence.
Comparatively, the sporulation of bacteria like Clostridium difficile presents a more formidable challenge due to the spores' resistance to routine cleaning agents. C. difficile spores can persist on surfaces for months, necessitating specialized sporicidal agents such as chlorine-based disinfectants (1,000–5,000 ppm) or UV-C light treatment. This highlights the importance of distinguishing between non-sporulating and sporulating bacteria in infection control protocols. While S. epidermidis management focuses on biofilm disruption, spore-forming bacteria require a dual approach: spore eradication and vegetative cell control.
In conclusion, the absence of sporulation in S. epidermidis fundamentally differentiates it from spore-forming bacteria like Bacillus and Clostridium species. This distinction influences both its survival strategies and the methods required to control it. While S. epidermidis relies on biofilms and antibiotic resistance, spore-forming bacteria leverage sporulation for long-term survival. Clinicians and researchers must tailor their approaches accordingly, using standard disinfection for S. epidermidis and sporicidal measures for spore-forming pathogens. This comparative understanding enhances infection prevention and treatment efficacy across diverse bacterial threats.
Can Haploid Cells Form Spores Through Meiosis? Exploring the Process
You may want to see also
Frequently asked questions
No, Staphylococcus epidermidis (S. epidermidis) does not produce spores. It is a non-spore-forming bacterium.
S. epidermidis lacks the genetic capability to form spores, even under stressful environmental conditions.
S. epidermidis survives through biofilm formation, which protects it from harsh conditions, and by adapting to its environment, such as the human skin.































